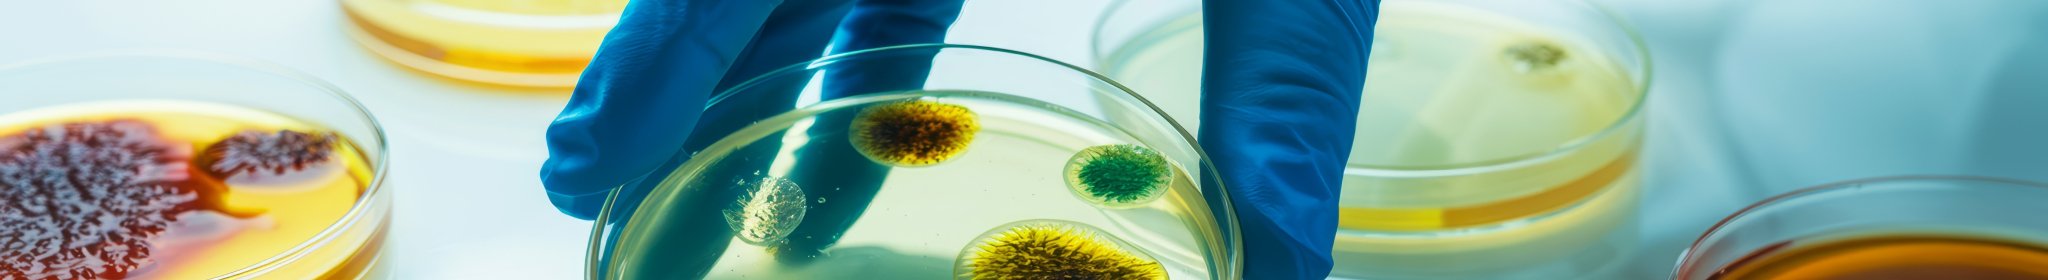
bateria_adobestock_1896018360.jpeg

Research
Research can take many forms, but for us this means the development of new equipment or techniques used in light microscopy, electron microscopy, metrology, defence, analytical instrumentation or any other optics applications. The type of product that may be required is dictated by the application or equipment but could be anything from our product range, be it standard or custom made.
Related Products & Applications